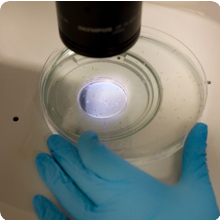
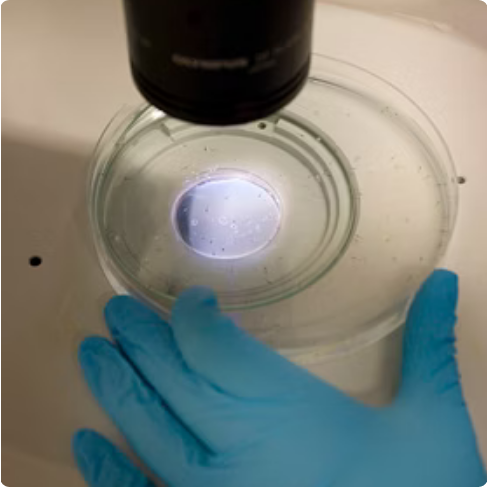

Robust, GLP-compliant data to support REACH, biocides, plant protection product(PPPs), and feed additives registrations worldwide — delivered on time, with scientific confidence.

In an increasingly demanding regulatory landscape, assessing the environmental impact of chemical substances and plant protection products (PPPs) is critical for securing market approval. Aquatic ecotoxicology studies evaluate potential risks to organisms and ecosystems, providing the robust scientific data required for environmental risk assessments.
Studies conducted in full accordance with OECD guidelines and Good Laboratory Practice standards. ViewChemicals and Food Additives and Phytosanitary Products certificates.
Data packages designed for REACH, biocides, PPPs, chemical, and feed additive registrations worldwide.
Comprehensive studies spanning, plants, invertebrates, and vertebrates (fish) across aquatic ecosystems.
Algae are the foundational producers of aquatic ecosystems. Our OECD 201 – Algae Growth Inhibition study assesses the effects of test substances on algal growth, providing essential data for environmental risk assessments of chemical substances and plant protection products (PPPs).
Algae Growth Inhibition — evaluates effects on growth rate of green algae Raphidocelis subcapitata.

Daphnia magma are key invertebrate consumers in freshwater ecosystems. Our GLP-compliant studies assess both acute and reproduction toxicity.

Determines the 48-hour immobilisation concentration (EC₅₀) of test substances on Daphnia magna, providing acute toxicity data for regulatory submissions.
Evaluates the effects of prolonged exposure on Daphnia reproduction over 21 days, generating chronic toxicity endpoints for comprehensive risk assessment.
Fish are the top vertebrate consumers in aquatic ecosystems. Our OECD-compliant fish studies cover acute, early-life stage, and embryo toxicity endpoints.

Determines the 96-hour lethal concentration (LC₅₀) in fish, a core acute toxicity endpoint for chemical and PPP registrations.

Assesses effects on fish from egg through juvenile development, providing chronic toxicity data for long-term environmental risk assessment.

An alternative acute toxicity test using fish embryos, reducing vertebrate use while delivering robust regulatory data.

Backed by experienced scientific teams, we ensure accurate monitoring of test substances. We provide reliable and flexible study designs, even for challenging substances — combining scientific excellence, GLP compliance, and operational efficiency to generate robust data packages.
Experienced scientific teams ensure accurate monitoring of test substances and reliable, flexible study designs — even for challenging substances.
All studies conducted in full accordance with OECD guidelines and Good Laboratory Practice, ensuring data integrity for regulatory submissions.
We help you meet submission deadlines, reduce risk, and accelerate your path to market with streamlined project execution.
We support your project at every stage, from initial study design through final regulatory submission.

Tailored study designs aligned with your specific regulatory requirements and submission timelines.

Rigorous GLP-compliant study conduct with full documentation and quality assurance throughout.

Accurate monitoring and verification of test substance concentrations to ensure data reliability.

Expert analysis and interpretation of results to support your environmental risk assessment.

Complete, regulatory-ready reports designed to meet submission requirements worldwide.
Our facilities can host the full range of aquatic ecotoxicology studies. We have analytical resources and GLP infrastructure to maintain our own cultures of algae and daphnia, as well as a fish facility that provides the necessary organisms

Whether you need a single study or a full testing program, we help you generate regulatory-ready ecotoxicology data — on time and with confidence. Speak to our experts today and take the next step toward market approval.
Consult with our experienced scientific team about your specific regulatory needs and study requirements.
Get a tailored proposal for your aquatic ecotoxicology testing program, designed to meet your timeline and budget.